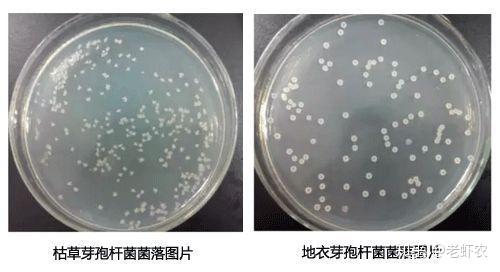
水产养殖常用几种"芽孢杆菌"总结大全!

凝结芽孢杆菌饭前饭后

凝结芽孢杆菌
图片尺寸650x350
凝结芽孢杆菌的特点,作用机制及生物学功能
图片尺寸640x480
凝结芽孢杆菌
图片尺寸1280x1280
凝结芽孢杆菌的作用原来这么多!
图片尺寸1096x588
芽孢杆菌形态特征doc
图片尺寸920x1302
水产养殖常用几种"芽孢杆菌"总结大全!
图片尺寸500x272
科普什么是凝结芽孢杆菌
图片尺寸1440x800
成都通威水产科技有限公司成功建立凝结芽孢杆菌快速检测技术
图片尺寸600x479
凝结芽孢杆菌lactospore
图片尺寸300x300
认识各种益生菌:丁酸梭菌,嗜酸乳杆菌,凝结芽孢杆菌,枯草芽孢
图片尺寸641x481凝结芽孢杆菌的作用
图片尺寸581x376
凝结芽孢杆菌小科普
图片尺寸514x514
地衣芽孢杆菌对植物和凝结芽孢杆菌的区别
图片尺寸800x320目前,可利用的芽孢杆菌有:枯草芽孢杆菌,凝结芽孢杆菌,缓慢芽孢杆菌
图片尺寸404x326
爽舒宝 凝结芽孢杆菌活菌片 0.35g*30片
图片尺寸380x380
芽孢杆菌形态特征(内容充实)
图片尺寸433x479
如何辨别真假凝结芽孢杆菌?_肠道
图片尺寸1080x1440
凝结芽孢杆菌bc01
图片尺寸1037x905
一种凝结芽孢杆菌产的细菌素及其应用的制作方法
图片尺寸630x623
食品界的选秀之星-凝结芽孢杆菌bc1031_生合生物科技(扬州)有限公司
图片尺寸745x521
猜你喜欢:凝结芽孢杆菌活菌片凝结芽孢杆菌菌落凝结芽孢杆菌凝结芽孢杆菌菌落形态凝结芽孢杆菌图片蜡样芽孢杆菌活菌胶囊芽孢杆菌活菌片说明书地衣芽孢杆菌活菌胶囊地衣芽孢杆菌活菌颗粒地衣芽孢杆菌活菌片凝结芽孢杆菌镜检图片芽孢杆菌贝莱斯芽孢杆菌爽肤宝芽孢杆菌活菌片地衣芽孢杆菌胶囊蜡样芽孢杆菌片巨大芽孢杆菌地衣芽孢杆菌蜡样芽孢杆菌苏云金芽孢杆菌解淀粉芽孢杆菌芽孢杆菌图片多粘类芽孢杆菌纳豆芽孢杆菌苏云金芽孢杆菌图片炭疽芽孢杆菌芽孢杆菌图片显微镜炭疽芽孢杆菌图片芽孢杆菌图片手绘图炭疽芽孢杆菌革兰染色腿上紫癜fgo美图 冲田总司动漫女生霸气 冷女迈威智能初中女生自拍照银百高速全图高清儿童防诈骗简笔画简单的小花园画虎须菖蒲开花工业风格图片大全顺德青年粤剧团血族第四季电视剧